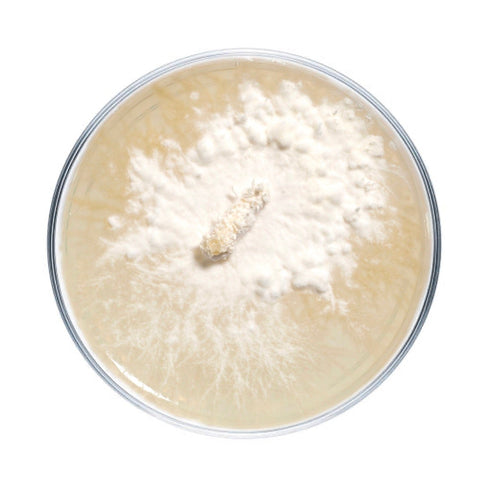
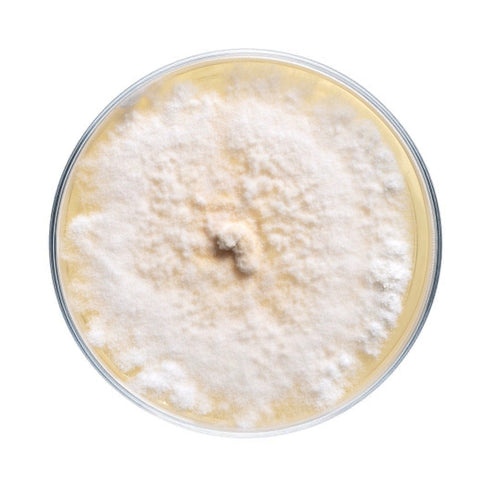
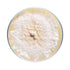
Lion's Mane Mushroom Plate Culture

- Home
- Lion's Mane Mushroom Plate Culture
Lion's Mane Mushroom Plate Culture

Species difficulty | Beginner |
Culture format | Agar plate |
Lab skills | Intermediate |
Shelf life | 6 months (refrigerated) |
Plate cultures are ideal for growers looking to make master bags, inoculate grain, make liquid culture, or make more plates.
Our lion's mane plates are made to order in our in-house lab using medical-grade petri dishes. If properly stored upon arrival, they have a shelf life of approximately 6 months. Lion's mane plates should be stored in the refrigerator to maintain viability. Note that mycelium cultures require basic lab skills. Handle using sterile technique to prevent contamination.
For complete descriptions of available lion's mane strains, click on the names below.
-
Hericium erinaceus. A very productive commercial lion's mane strain that forms dense "pom pom" fruiting bodies. Fruits best in cooler temperatures, 1/2-1 lb yield on first flush off of 5 lb supplemented sawdust with consistent subsequent flushes over several months.
-
Hericium erinaceus. A reliable lion's mane commercial strain from Washington with similar fruiting conditions as our HE1 and HE3.
-
Hericium erinaceus. A "showy" strain of Lion's Mane that produces commercially viable flushes of less uniformed fruiting bodies adding variation to your lion's mane boxes.
-
Hericium corralloides. A commercially productive lion's mane strain of comb tooth from Mossy Creek in Tennessee. Unlike the dense "pom poms" of H. erinaceus, this strain produces large, coral-like fruiting bodies with branching spines.
-
Hericium americanum. Also known as Bear's Head, this strain features longer, icicle-like spines but resembles erinaceus when young. Often found on hardwoods but sometimes on conifers. This strain comes from the Pacific Northwest.
-
Hericium americanum. A lion's mane strain cultured from a wild specimen found in Maine.
You may also like
- Reviews
- Questions
Thank you for submitting a review!
Your input is very much appreciated. Share it with your friends so they can enjoy it too!

Lion’s Mane
Great experience. The plate was clean, and completely colonized as expected. It was delivered earlier than the listed “ as late as” date, so that’s always nice.
NSHE3 Tree Beard
Clean and beautifully covered Lions Mane plate arrived in the expected time and has lead to many more successful colonization of plates and master grain jars. Started with the NSHE3 Tree Beard and definitely will be trying the other strains soon.